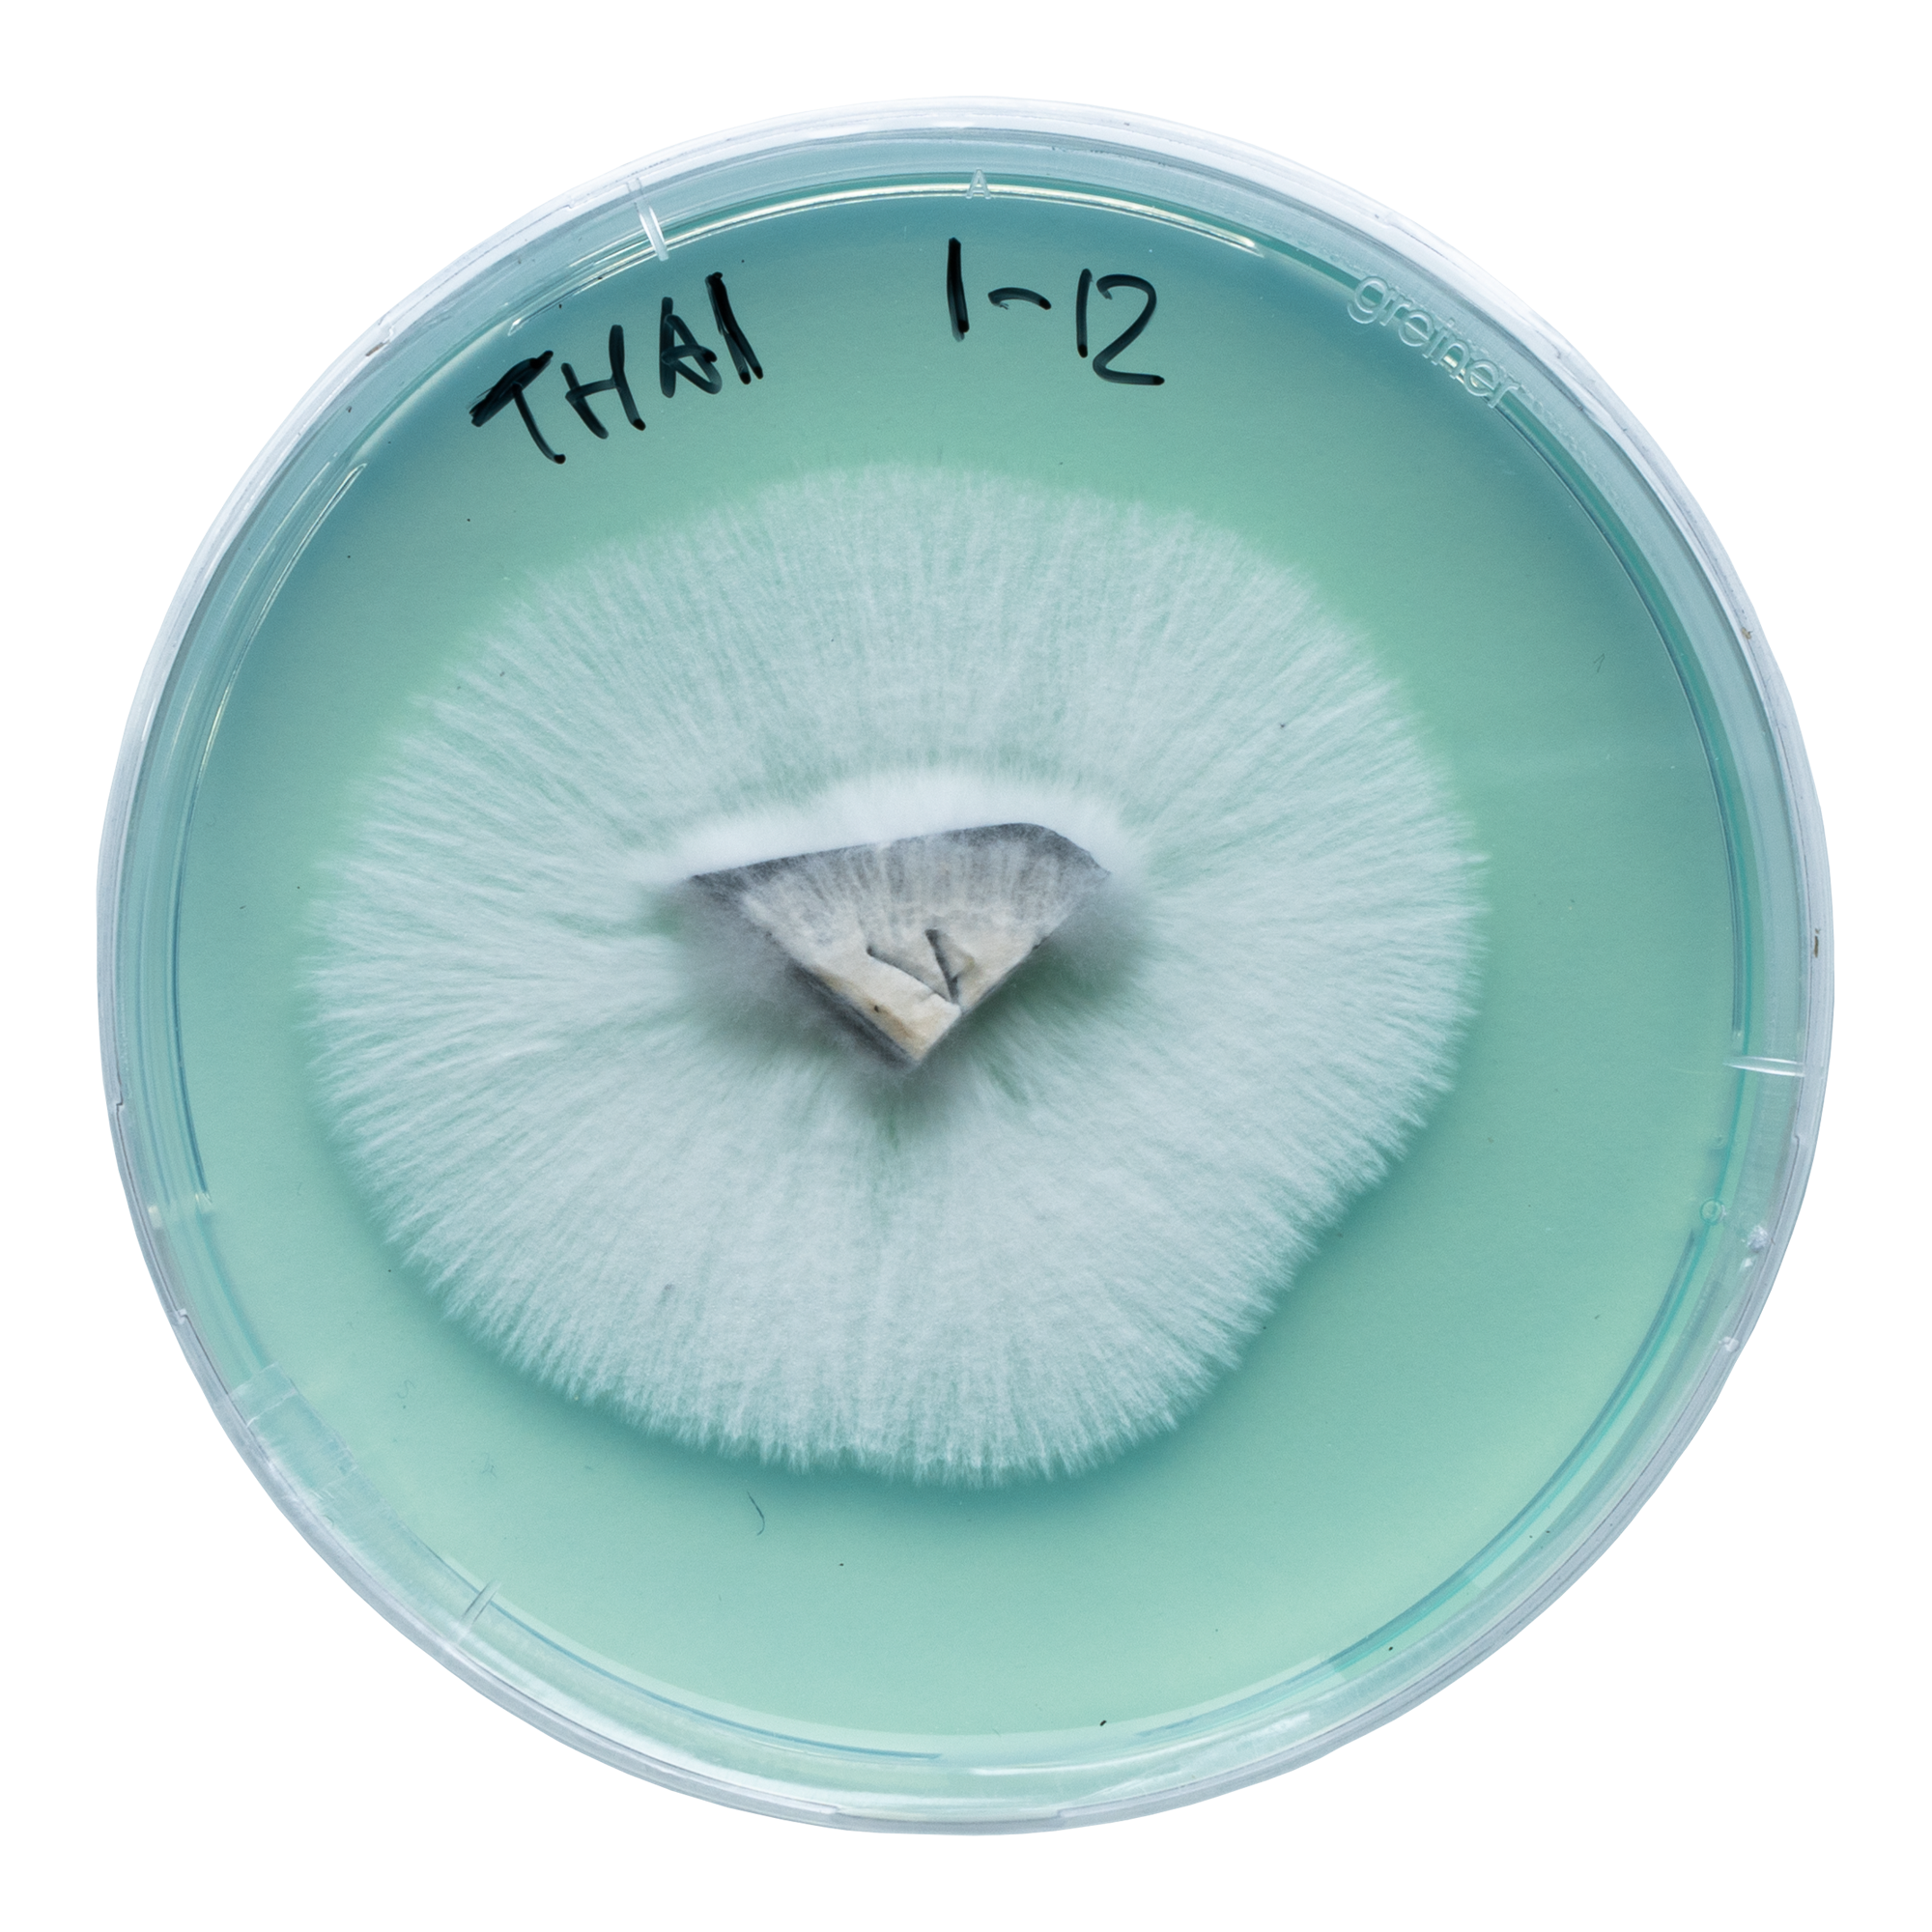

Setas mágicas Thai: orígenes y genética
La cepa Thai es una de las muchas cepas que el famoso etnomicólogo John Allen, también conocido como MJshroomer, recolectó mientras exploraba la isla tailandesa de Koh Samui.
Aunque esta variedad muestra similitudes con la cepa oficial de Koh Samui, también existen diferencias evidentes. A diferencia de las setas de Koh Samui, que suelen ser cortas y gruesas, la Thai tiene un aspecto más clásico de Psilocybe cubensis. Esto significa tallos algo más largos y sombreros redondos que se aplanan gradualmente. A medida que maduran, los sombreros también pueden adoptar formas cóncavas.
Debido a que esta cepa a menudo produce impresionantes grupos de primordios, las setas pueden ser algo más cortas que las de otras cepas de Psilocybe cubensis.
Desarrollo del cultivo líquido Thai de Acid Shroomz
Desarrollamos nuestro cultivo líquido Thai a través de una serie de pasos. El proceso comenzó con una jeringa de esporas Thai, que utilizamos para inyectar esporas directamente en un sustrato de grano. Este paso inicial tenía como objetivo determinar la viabilidad de las esporas.
Después de unos días, observamos el primer micelio, y unas semanas más tarde, pudimos ver los primeros frutos. De estos frutos, clonamos algunos especímenes prometedores en placas de agar para un mayor aislamiento genético. Después de algunas rondas de aislamiento, tuvimos algunos cultivos puros que fueron probados por su rendimiento. El cultivo de mejor rendimiento fue seleccionado como la base para nuestros cultivos líquidos.
Nuestro cultivo Thai resultante crece agresivamente, ofrece una alta resistencia a la contaminación y, por lo general, produce múltiples cosechas. Las setas a menudo tienen una estructura firme con sombreros de color marrón oscuro que se vuelven de color caramelo a medida que maduran. En cuanto a los efectos, considere términos como alegre, visual y potencia media. Tanto los principiantes como los usuarios avanzados estarán satisfechos con los impresionantes grupos de primordios y las características de crecimiento.
Contenido del producto
Cada jeringa Thai contiene 20 ml de micelio vivo en una solución nutritiva cuidadosamente formulada. La jeringa es un modelo B. Braun de alta calidad para una manipulación e inoculación precisas.
Además, el embalaje del producto contiene dos toallitas con alcohol isopropílico al 70%, una aguja de jeringa estéril de 16G y un folleto de instrucciones.
Cómo utilizar una jeringa de cultivo líquido Thai
Para obtener más información, consulta nuestros artículos sobre el uso de jeringas de cultivo líquido.
Precauciones de seguridad y manipulación
Al manipular la jeringa de cultivo líquido Thai, es crucial seguir las precauciones de seguridad adecuadas para evitar la contaminación y garantizar un proceso de crecimiento exitoso. Aquí hay algunas pautas generales a tener en cuenta:
- Siempre manipule la jeringa en un ambiente limpio y estéril.
- Use guantes de nitrilo sin polvo y una mascarilla para evitar la contaminación.
- Asegúrese de que haya poco o ningún flujo de aire en su lugar de trabajo.
- Evite tocar la aguja o el cultivo líquido directamente para mantener la esterilidad.
- Guarde la jeringa en un refrigerador a 4-7°C para prolongar su vida útil.
Accesorios opcionales
Considere la posibilidad de utilizar una cabina de flujo laminar o una caja de aire quieto (SAB) para mayor esterilidad durante la inoculación de sustratos.
Datos generales
| Especie | Psilocybe cubensis |
| Genética | Variedad de koh samui, Tailandia |
| Esporas | De púrpura a marrón |
| Aplicaciones | Microscopía, investigación y propósitos de taxonomía. |
| Nivel de habilidad | Principiante |
| Velocidad de colonización | Rápida |
| Potencia | Media |
Datos de cultivo
| Fase de desove | |
| Sustratos adecuados | Granos esterilizados como arroz integral, centeno, avena, mijo, palomitas de maíz o semillas para pájaros silvestres. |
| Tiempo de colonización | 9-14 días (tarro de litro lleno 2/3 / 27°C / agitado al 25-33% de colonización). |
| Temperatura | 25-27°C |
| Luz | Poca luz u oscuridad. |
| Fase de fructificación | |
| Sustratos adecuados | Estiércol, fibra de coco, CVG o paja (adecuadamente hidratados y tratados térmicamente). |
| Temperatura | 21-25°C |
| Humedad relativa | 80-100% |
| Intercambio de aire fresco (FAE) | Asegure un buen flujo de aire sin secar el sustrato. |
| Luz | Luz diurna indirecta o luz artificial suave (aproximadamente 6500 Kelvin). |
Notas
Este producto tiene una vida útil limitada y no es elegible para devolución. Para obtener más información, consulta nuestra página sobre el período de reflexión y las devoluciones.

Valoraciones
Aún no hay reseñas